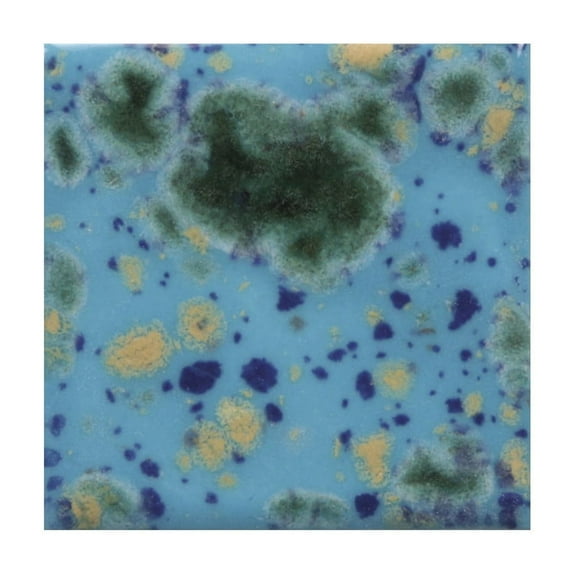
Sax Colorburst Glaze, Blue Caprice, 1 Pint

Sax(317)
Uses item details. Price when purchased online
Sax True Flow Non-Toxic Water Soluble Block Printing Ink - 5 Oz. - Black $18.16 Was $27.46

Now$1816
current price Now $18.16, Was $27.46$27.46
Sax True Flow Non-Toxic Water Soluble Block Printing Ink - 5 Oz. - Black
34.7 out of 5 Stars. 3 reviews
Sax Multi-Media Varnish, Matte Finish, 1 Gallon $76.87

$7687
current price $76.87Sax Multi-Media Varnish, Matte Finish, 1 Gallon
15 out of 5 Stars. 1 reviews
Sax True Flow Water Soluble Block Printing Ink, 8 Ounces, Turquoise $27.44

$2744
current price $27.44Sax True Flow Water Soluble Block Printing Ink, 8 Ounces, Turquoise
15 out of 5 Stars. 1 reviews
Sax T-Shirt 100% Cotton Medium White $24.48

$2448
current price $24.48Sax T-Shirt 100% Cotton Medium White
Sax Sulphite Spiral Binding Artists Sketch Diary, 50 lbs, 8-1/2 x 11 Inches, 100 Sheets, White $22.23

$2223
current price $22.23Sax Sulphite Spiral Binding Artists Sketch Diary, 50 lbs, 8-1/2 x 11 Inches, 100 Sheets, White
314.6 out of 5 Stars. 31 reviews
Sax Gloss Glaze, Snow White, 1 Pint $29.42

$2942
current price $29.42Sax Gloss Glaze, Snow White, 1 Pint
23 out of 5 Stars. 2 reviews
Sax True Flow Water Soluble Block Printing Ink, 5 Ounce Tube, Orange $24.74

$2474
current price $24.74Sax True Flow Water Soluble Block Printing Ink, 5 Ounce Tube, Orange
15 out of 5 Stars. 1 reviews
Sax Multi-Media Varnish, Matte Finish, 1 Quart $42.55

$4255
current price $42.55Sax Multi-Media Varnish, Matte Finish, 1 Quart
Sax True Flow Water Soluble Block Printing Ink, 5 Ounce Tube, Gold $24.74

$2474
current price $24.74Sax True Flow Water Soluble Block Printing Ink, 5 Ounce Tube, Gold
15 out of 5 Stars. 1 reviews
Sax Versatemp Premium Heavy-Bodied Tempera Paint, 1 Gallon, Turquoise $51.82

$5182
current price $51.82Sax Versatemp Premium Heavy-Bodied Tempera Paint, 1 Gallon, Turquoise
Sax True Flow Water Soluble Block Printing Ink, 5 Ounce Tube, Green $28.57

$2857
current price $28.57Sax True Flow Water Soluble Block Printing Ink, 5 Ounce Tube, Green
14 out of 5 Stars. 1 reviews
Sax True Flow Fluid Acrylic Paint, Assorted Colors, Pints, Set of 12 $93.17

$9317
current price $93.17Sax True Flow Fluid Acrylic Paint, Assorted Colors, Pints, Set of 12
184.8 out of 5 Stars. 18 reviews
11 x 14 in. Tracing Paper Pad - 50 Sheets, White, Pack 50

11 x 14 in. Tracing Paper Pad - 50 Sheets, White, Pack 50
Sax True Flow Water Soluble Block Printing Ink, 8 Ounces, Magenta $22.72 Was $27.45

Now$2272
current price Now $22.72, Was $27.45$27.45
Sax True Flow Water Soluble Block Printing Ink, 8 Ounces, Magenta
Sax True Flow Water Soluble Block Printing Ink, 8 Ounces, Primary Blue $29.39

$2939
current price $29.39Sax True Flow Water Soluble Block Printing Ink, 8 Ounces, Primary Blue
Sax Optimium White Taklon Brushes, Flat Type, Long Handle, Size 8, Pack of 3 $26.66 Was $29.64

Now$2666
current price Now $26.66, Was $29.64$29.64
Sax Optimium White Taklon Brushes, Flat Type, Long Handle, Size 8, Pack of 3
Sax True Flow Non-Toxic Water Soluble Block Printing Ink- Black $33.63

$3363
current price $33.63Sax True Flow Non-Toxic Water Soluble Block Printing Ink- Black
Sax Acrylic Gloss Medium Preparation and Protection, 1 Gallon $71.12

$7112
current price $71.12Sax Acrylic Gloss Medium Preparation and Protection, 1 Gallon
15 out of 5 Stars. 1 reviews
Sax Versatemp Premium Heavy-Bodied Tempera Paint, 1 Gallon, Green $39.37

$3937
current price $39.37Sax Versatemp Premium Heavy-Bodied Tempera Paint, 1 Gallon, Green
12 out of 5 Stars. 1 reviews
Sax Gloss Glaze, Sassy Yellow, 1 Pint $29.42

$2942
current price $29.42Sax Gloss Glaze, Sassy Yellow, 1 Pint
22.5 out of 5 Stars. 2 reviews
Sax True Flow Water Soluble Block Printing Ink, 1 Pint Jar, Magenta $33.48

$3348
current price $33.48Sax True Flow Water Soluble Block Printing Ink, 1 Pint Jar, Magenta
12 out of 5 Stars. 1 reviews
Sax Special Melton Mount Board, 22 x 28 Inches, Black/White, Pack of 20 $125.95 $125.95/count

$12595
current price $125.95$125.95/count
Sax Special Melton Mount Board, 22 x 28 Inches, Black/White, Pack of 20
Sax True Flow Heavy Body Acrylic Paint, Quart, Blockout White $27.28

$2728
current price $27.28Sax True Flow Heavy Body Acrylic Paint, Quart, Blockout White
15 out of 5 Stars. 1 reviews
Sax Heavy Body Acrylic Paint, Half Gallons, Assorted Colors, Set of 6 $165.75

$16575
current price $165.75Sax Heavy Body Acrylic Paint, Half Gallons, Assorted Colors, Set of 6
74.3 out of 5 Stars. 7 reviews
Sax True Flow Water Soluble Block Printing Ink, 5 Ounce Tube, Primary Blue $24.11

$2411
current price $24.11Sax True Flow Water Soluble Block Printing Ink, 5 Ounce Tube, Primary Blue
14 out of 5 Stars. 1 reviews
Sax Colorburst Glaze, Mystic Jade, 1 Pint $23.96 Was $26.74

Now$2396
current price Now $23.96, Was $26.74$26.74
Sax Colorburst Glaze, Mystic Jade, 1 Pint
11 out of 5 Stars. 1 reviews
Sax True Flow Multi-Media Varnish, Gloss Finish, 1 Gallon $89.60 $89.60/gl

$8960
current price $89.60$89.60/gl
Sax True Flow Multi-Media Varnish, Gloss Finish, 1 Gallon
Sax 2024076 0.5 in. Optimum Golden Synthetic Taklon Paint Brushes Long - Flat - Set of 3 $24.18

$2418
current price $24.18Sax 2024076 0.5 in. Optimum Golden Synthetic Taklon Paint Brushes Long - Flat - Set of 3
Sax White Bristle Brush School Pack, Flat Type, Long Handle, Assorted Sizes, Set of 216 $238.28 Was $269.90

Now$23828
current price Now $238.28, Was $269.90$269.90
Sax White Bristle Brush School Pack, Flat Type, Long Handle, Assorted Sizes, Set of 216
Sax Oval Wash Ox Hair Paint Brushes with Short Handles,1 Inch, Pack of 3 $26.05 Was $36.31

Now$2605
current price Now $26.05, Was $36.31$36.31
Sax Oval Wash Ox Hair Paint Brushes with Short Handles,1 Inch, Pack of 3
Sax Lead-Free Non-Toxic Gloss True Flow Glaze - Raspberry Whip - 1 Pt. $28.59

$2859
current price $28.59Sax Lead-Free Non-Toxic Gloss True Flow Glaze - Raspberry Whip - 1 Pt.
Sax Watercolor Pad, 140 lb, 18 x 24 Inches, White, 12 Sheets $25.60 Was $33.50

Now$2560
current price Now $25.60, Was $33.50$33.50
Sax Watercolor Pad, 140 lb, 18 x 24 Inches, White, 12 Sheets
23 out of 5 Stars. 2 reviews
Sax Colorburst Glaze, Blue Caprice, 1 Pint $23.96 Was $34.44
Now$2396
current price Now $23.96, Was $34.44$34.44
Sax Colorburst Glaze, Blue Caprice, 1 Pint
24 out of 5 Stars. 2 reviews
Sax Gloss Glaze, Sassy Yellow, 1 Gallon $83.69

$8369
current price $83.69Sax Gloss Glaze, Sassy Yellow, 1 Gallon
15 out of 5 Stars. 1 reviews
Sax True Flow Water Soluble Block Printing Ink, 5 Ounce Tube, Violet $27.34

$2734
current price $27.34Sax True Flow Water Soluble Block Printing Ink, 5 Ounce Tube, Violet
Sax Gloss Glaze, Tahiti Blue, 1 Pint $32.20

$3220
current price $32.20Sax Gloss Glaze, Tahiti Blue, 1 Pint
24 out of 5 Stars. 2 reviews
Sax True Flow Non-Toxic Water Soluble Block Printing Ink - Red - 5 Oz.

Sax True Flow Non-Toxic Water Soluble Block Printing Ink - Red - 5 Oz.
Sax True Flow Lead-Free Non-Toxic Gloss Glaze, 1 pt, Raspberry Whip $23.84 $23.84/count

$2384
current price $23.84$23.84/count
Sax True Flow Lead-Free Non-Toxic Gloss Glaze, 1 pt, Raspberry Whip
Sax Premium Heavy-Bodied Acrylic Paint, 4 Ounce Jars, Assorted Metallic Colors, Set of 6 $36.13 Was $40.64

Now$3613
current price Now $36.13, Was $40.64$40.64
Sax Premium Heavy-Bodied Acrylic Paint, 4 Ounce Jars, Assorted Metallic Colors, Set of 6
12 out of 5 Stars. 1 reviews




